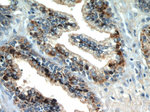
STK4/MST1 Antibody in Immunohistochemistry (Paraffin) (IHC (P))

Search
Proteintech
STK4/MST1 Polyclonal Antibody
{{$productOrderCtrl.translations['antibody.pdp.commerceCard.promotion.promotions']}}
{{$productOrderCtrl.translations['antibody.pdp.commerceCard.promotion.viewpromo']}}
{{$productOrderCtrl.translations['antibody.pdp.commerceCard.promotion.promocode']}}: {{promo.promoCode}} {{promo.promoTitle}} {{promo.promoDescription}}. {{$productOrderCtrl.translations['antibody.pdp.commerceCard.promotion.learnmore']}}
产品信息
22245-1-AP
种属反应
已发表种属
宿主/亚型
分类
类型
抗原
偶联物
形式
浓度
规格
纯化类型
保存液
内含物
保存条件
运输条件
产品详细信息
Immunogen sequence: RRDETMQPA KPSFLEYFEQ KEKENQINSF GKSVPGPLKN SSDWKIPQDG DYEFLKSWTV EDLQKRLLAL (383-451 aa encoded by BC093768)
靶标信息
STK4 (MST1) is a serine/threonine kinase which may be involved in apoptosis. It is possible that this protein induces the chromatin condensation observed in this process. STK4 is a stress-activated, pro-apoptotic kinase which, following caspase-cleavage, enters the nucleus and induces chromatin condensation followed by internucleosomal DNA fragmentation. It is a key component of the Hippo signaling pathway which plays a pivotal role in organ size control and tumor suppression by restricting proliferation and promoting apoptosis. The core of this pathway is composed of a kinase cascade wherein STK3/MST2 and STK4/MST1, in complex with its regulatory protein SAV1, phosphorylates and activates LATS1/2 in complex with its regulatory protein MOB1, which in turn phosphorylates and inactivates YAP1 oncoprotein and WWTR1/TAZ. Phosphorylation of YAP1 by LATS2 inhibits its translocation into the nucleus to regulate cellular genes important for cell proliferation, cell death, and cell migration. STK3/MST2 and STK4/MST1 are required to repress proliferation of mature hepatocytes, to prevent activation of facultative adult liver stem cells (oval cells), and to inhibit tumor formation.
仅用于科研。不用于诊断过程。未经明确授权不得转售。
生物信息学
蛋白别名: EC 2.7.11.1; hippo homolog; kinase MST1; kinase responsive to stress 2; Mammalian STE20-like protein kinase 1; mammalian sterile 20-like 1; MST-1; Serine/threonine-protein kinase 4; Serine/threonine-protein kinase Krs-2; STE20-like kinase MST1; sterile 20-like kinase 1; TIIAC; unnamed protein product; Yeast Sps1/Ste20-related kinase 3
基因别名: AI447339; AU020804; Kas-2; KRS2; MST1; STK4; YSK3
UniProt ID: (Human) Q13043, (Mouse) Q9JI11
Entrez Gene ID: (Human) 6789, (Rat) 311622, (Mouse) 58231